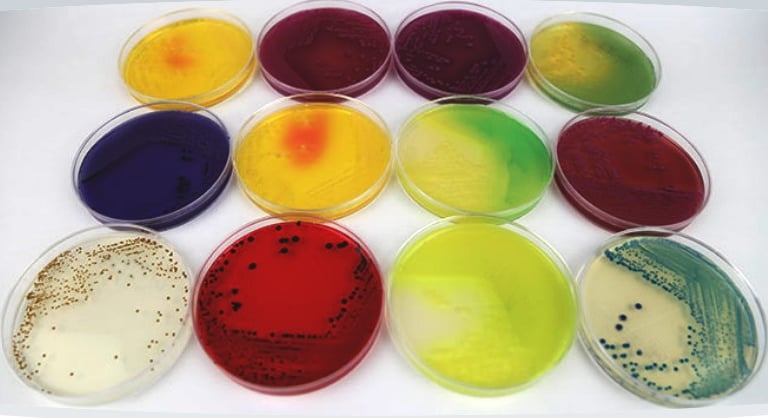
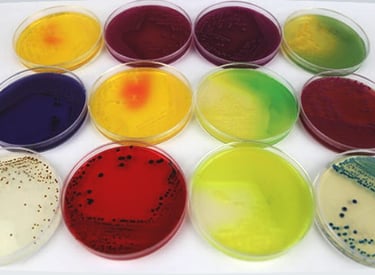

Microbiología
Ponemos a su alcance capacidades microbiológicas avanzadas respaldadas por especialistas certificados y laboratorios con infraestructura de última generación, asegurando evaluaciones precisas y confiables para sus procesos.
Contamos con personal con experiencia en análisis microbiológico, monitoreos ambientales, pruebas de esterilidad e identificación de microorganismos para ayudarle a entender sus necesidades en un área tan especializada como lo es microbiología.


Distribuidores Autorizados de DIBICO en:
Medios de Cultivo
Distribuimos medios de cultivo diseñados para diversas aplicaciones en microbiología y biotecnología.

Cepas Microbiológicas
Ofrecemos una variedad de cepas microbianas para investigación y aplicaciones industriales específicas.
Soluciones
Pruebas rápidas para E. coli (DBC)
Suplementos e ingredientes






Deshidratados
Preparados en frasco
Preparados en vial
Preparados en tubo
Preparados en placa
Contáctanos para una cotización.
Te ofreceremos un buen trato, con un precio competitivo en el mercado.
